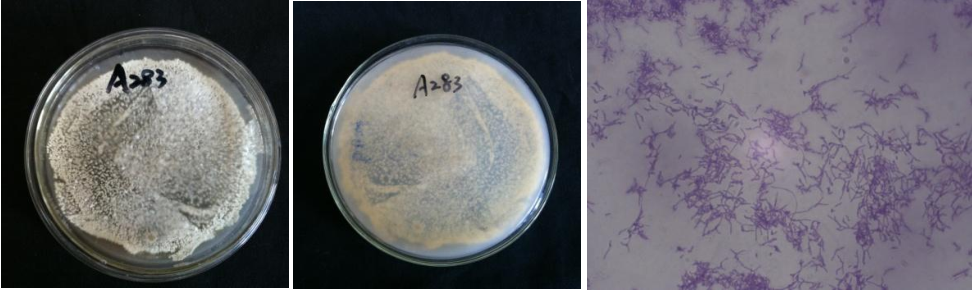

Loading...
| StrainNO | A283 |
| Classification | Nocardioides |
| 16s rDNA sequence | TGCTTAACACATGCAAGTCGAGCGGTAAGGCCTCTTCGGGGGTACACGAGCGGCGAACGGGTGAGTAACACGTGAGTAATCTGCC CATGGCTCTGGGATAAGCTCCCGAAAGGGTGTCTAATACCGGATATGACAGCTCCTCGCATGGGGTGGTTGTGGAAAGTTTTTTC GGCCATGGATGTGCTCGCGGCCTATCAGCTTGTTGGTGGGGTAATGGCCTACCAAGGCTTTGACGGGTAGCCGGCCTGAGAGGGT GACCGGTCACACTGGGACTGAGACACGGCCCAGACTCCTACGGGAGGCAGCAGTGGGGAATATTGGACAATGGGCGGAAGCCTGA TCCAGCAACGCCGCGTGAGGGATGACGGCCTTCGGGTTGTAAACCTCTTTCAGTACCGACTAAGCGAGAGTGACGGTAGGTACAG AAGAAGCACCGGCCAACTACGTGCCAGCAGCCGCGGTAATACGTAGGGTGCGAGCGTTGTCCGGAATTATTGGGCGTAAAGGGCT CGTAGGCGGTTTGTCGCGTCGGGAGTGAAAACATCGGGCTTAACTCGGTGCTTGCTTTCGATACGGGCAGACTTGAGGCATGCAG GGGAGAACGGAATTCCTGGTGTAGCGGTGAAATGCGCAGATATCAGGAGGAACACCGGTGGCGAAGGCGGTTCTCTGGGCATGTT CTGACGCTGAGGAGCGAAAGTGTGGGGAGCGAACAGGATTAGATACCCTGGTAGTCCACACCGTAAACGTTGGGCGCTAGGTGTG GGACCCTTCCACGGGTTCCGTGCCGTAGCTAACGCATTAAGCGCCCCGCCTGGGGAGTACGGCCGCAAGGCTAAAACTCAAAGGA ATTGACGGGGGCCCGCACAAGCGGCGGAGCATGCGGATTAATTCGATGCAACGCGAAGAACCTTACCTGGGTTTGACATACACGG GAAGCCCCTAGAGATAGGGGTCTCTTTGATACTCGTGTACAGGTGGTGCACGGCTTGTCGTCAGCTCGTGTCGTAGATGTTGGGT TAAGTCCCGCAACGAGGCAACCCTCGTTCCATGTTGCCAGCAAGTATGTTGGGACTCATGGAGCTTCCGGGGTCAACTCGAAGGA AGGTGGGATGACGCAAGTCATCATGCCCCTTATGTCCAGGGCTTCACGCATGCTACAATGGCCGGACAAAGGCTTCGATCCTGTA AGGGTAGCGAATCCCAAAAGCCGGTCTCAGTTCGGATTGGGGTCTGCAACTCGACCCCATGAAGTGGAGTCGCTAGTAATCGCAG ATCAGCAACGCTTCGGTGAATACGTTCCCGGGCCTTGACACACCGCCCGTCACGTCACGAAAGTCGGCAACACCCGAAGCCGGTG GCCTAACCCTTGTGGGGGGAGCCGTCGAAGGTGGGGCTGCGATTGGGACGAAGTCGAACAAGGAGCCGT |
| Strain Morphology Photos | |
| Morphological Description | Mycelia branch less;separation is not broken;mycelia all broken into irregular short cut secondary mycelia fine into curly growth;fracture;there is a larger near round spore colony on the short stalk |